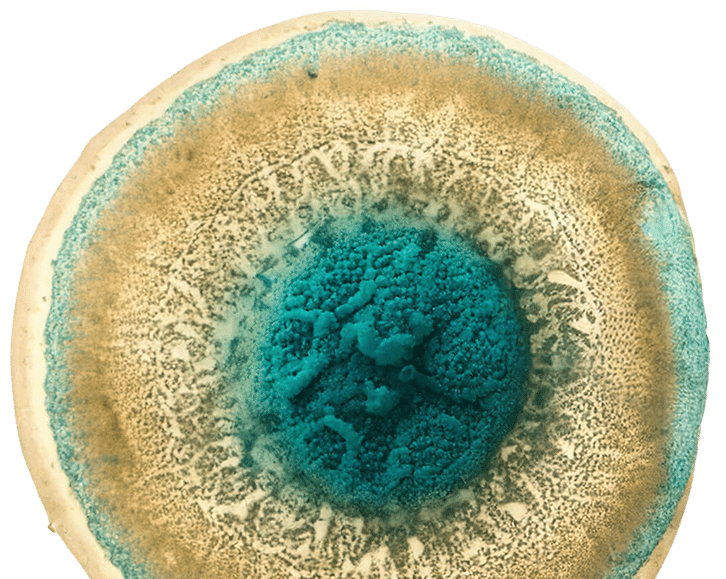

About Dezawa MuseCells® & Dezawa MuseExosomes®
Understanding the original Muse platform – from Prof. Mari Dezawa’s discovery to allogeneic IV cell therapy and Muse-derived exosomes now manufactured in Thailand.

From Discovery to the Dezawa Muse Platform
Muse cells (Multilineage-Differentiating Stress-Enduring cells) were discovered by Professor Mari Dezawa in Japan as rare endogenous cells with pluripotent-like behaviour, stress endurance and homing to damaged tissue. Over more than a decade, this discovery was translated into clinical-grade products: Dezawa MuseCells® (allogeneic IV Muse cell therapy) and Dezawa MuseExosomes® (Muse-derived, cell-free exosomes).
• Endogenous, adult-derived; no genetic reprogramming.
• Pluripotent-like: differentiation from single cells into derivatives of three germ layers.
• Stress-enduring and damage-sensing: survive stress, home to injured tissue. Non-tumorigenic in preclinical models (low telomerase, no teratoma formation).
• Endogenous, adult-derived; no genetic reprogramming.
• Pluripotent-like: differentiation from single cells into derivatives of three germ layers.
• Stress-enduring and damage-sensing: survive stress, home to injured tissue. Non-tumorigenic in preclinical models (low telomerase, no teratoma formation).
Dezawa MuseCells® – Allogeneic IV Muse Cell Therapy
Dezawa MuseCells® are allogeneic Muse cells developed under Prof. Dezawa’s protocols as an IV systemic therapy for multi-organ regenerative indications.
Key clinical concepts:
• Homing and structural integration into injured organs such as brain, heart, liver, kidney and cartilage.
• Dual action: in-vivo differentiation plus paracrine modulation (anti-inflammatory, anti- fibrotic, pro-angiogenic).
• Clinical domains under investigation include neurology (stroke, ALS, SCI, neonatal HIE), cardiology (AMI), liver and kidney fibrosis, orthopaedics/cartilage repair, and multi- organ healthy ageing concepts.
• Dual action: in-vivo differentiation plus paracrine modulation (anti-inflammatory, anti- fibrotic, pro-angiogenic).
• Clinical domains under investigation include neurology (stroke, ALS, SCI, neonatal HIE), cardiology (AMI), liver and kidney fibrosis, orthopaedics/cartilage repair, and multi- organ healthy ageing concepts.
Dezawa MuseExosomes® – Cell-Free Muse Signalling
Dezawa MuseExosomes® are exosomes derived specifically from Muse cells, carrying a biological cargo that reflects Muse-specific regenerative signalling rather than generic MSC
exosomes.
exosomes.

Positioning
• Designed as a cell-free extension of the Muse platform.
• Potential uses include maintenance after MuseCells® programs and integration into longevity, metabolic and dermato-regenerative
programs where appropriate.
• Positioned to support long-term tissue resilience within multi-modal hospital programs.
• Potential uses include maintenance after MuseCells® programs and integration into longevity, metabolic and dermato-regenerative
programs where appropriate.
• Positioned to support long-term tissue resilience within multi-modal hospital programs.
How Are Muse Cells Thought to Work?
1. IV dosing of Dezawa MuseCells® – allogeneic cells administered using indication- specific protocols.
2. Active homing to injury – S1P-S1PR2 axis enables Muse cells to migrate to damaged tissue instead of passively trapping in the lungs.
3. Engraftment and differentiation – cells integrate and differentiate into tissue-specific cell types (neural, cardiac, hepatic, renal, cartilage-related).
4. Paracrine signalling – release of molecules that reduce inflammation and fibrosis and support survival of bystander cells.
5. Functional improvement – early clinical trials report improvements in neurological scales, LV function and wound healing in selected indications.
Dezawa MuseExosomes® deliver a subset of these paracrine signals without administering whole cells, which may be advantageous for maintenance or for patients where cell therapy is not feasible.
2. Active homing to injury – S1P-S1PR2 axis enables Muse cells to migrate to damaged tissue instead of passively trapping in the lungs.
3. Engraftment and differentiation – cells integrate and differentiate into tissue-specific cell types (neural, cardiac, hepatic, renal, cartilage-related).
4. Paracrine signalling – release of molecules that reduce inflammation and fibrosis and support survival of bystander cells.
5. Functional improvement – early clinical trials report improvements in neurological scales, LV function and wound healing in selected indications.
Dezawa MuseExosomes® deliver a subset of these paracrine signals without administering whole cells, which may be advantageous for maintenance or for patients where cell therapy is not feasible.
Clinical Evidence Snapshot (Teaser)
Selected examples (more detail in /clinical-evidence):
• Randomized, placebo-controlled clinical trial of CL2020 (Muse cell product) in subacute ischemic stroke.
• First-in-human trial of Muse cells in acute myocardial infarction (AMI).
• Neonatal hypoxic-ischemic encephalopathy (HIE) and amyotrophic lateral sclerosis (ALS) early-phase clinical studies.
• Liver and kidney fibrosis models (mouse and large-animal) and osteochondral repair in orthopaedic models.
• First-in-human trial of Muse cells in acute myocardial infarction (AMI).
• Neonatal hypoxic-ischemic encephalopathy (HIE) and amyotrophic lateral sclerosis (ALS) early-phase clinical studies.
• Liver and kidney fibrosis models (mouse and large-animal) and osteochondral repair in orthopaedic models.
Limitations & Responsible Use
Dezawa MuseCells® and Dezawa MuseExosomes® are advanced regenerative therapies rather than standard of care in most conditions. Evidence levels differ by indication, and long-term data are still maturing. Programs must be adjuncts to guideline-based care, not replacements. Usage should be restricted to licensed hospitals and centres with ethics approval and adherence to product IFU and national regulations.
Muse Cells vs Conventional Stem Cells
Muse cells
Conventional MSCs
Origin:
Differentiation and Behaviour:
Safety Profile:
Muse cells are a defined subpopulation within adult tissues.
Muse cells demonstrate pluripotent-like differentiation from single cells and can integrate structurally into damaged tissue in models.
Muse cells are endogenous and have shown low tumour-forming potential in preclinical models.
Conventional MSCs are heterogeneous cell mixtures.
Pluripotent cells (such as embryonic or induced pluripotent stem cells) are reprogrammed cells.
Pluripotent cells (such as embryonic or induced pluripotent stem cells) are reprogrammed cells.
Conventional MSCs mainly act via paracrine mechanisms with limited durable engraftment.
Pluripotent cells carry a known risk of teratoma formation if not carefully controlled.
These distinctions help explain why Muse cells are considered a separate
category within regenerative medicine.
category within regenerative medicine.
Technology Transfer to Thailand
To make Muse technology accessible in Asia under controlled conditions, technology
transfer agreements have enabled Dezawa MuseCells® and Dezawa MuseExosomes®
manufacturing to be established in Thailand via Innobelle.
transfer agreements have enabled Dezawa MuseCells® and Dezawa MuseExosomes®
manufacturing to be established in Thailand via Innobelle.
Key aspects include:
• Use of defined, originator-derived protocols.
• Implementation of quality control systems tailored to cell-based products.
• Collaboration with hospital-based clinicians and researchers.
• Implementation of quality control systems tailored to cell-based products.
• Collaboration with hospital-based clinicians and researchers.
This framework supports the development of Muse-related programs that are both scientifically grounded and aligned with local regulations and ethics.